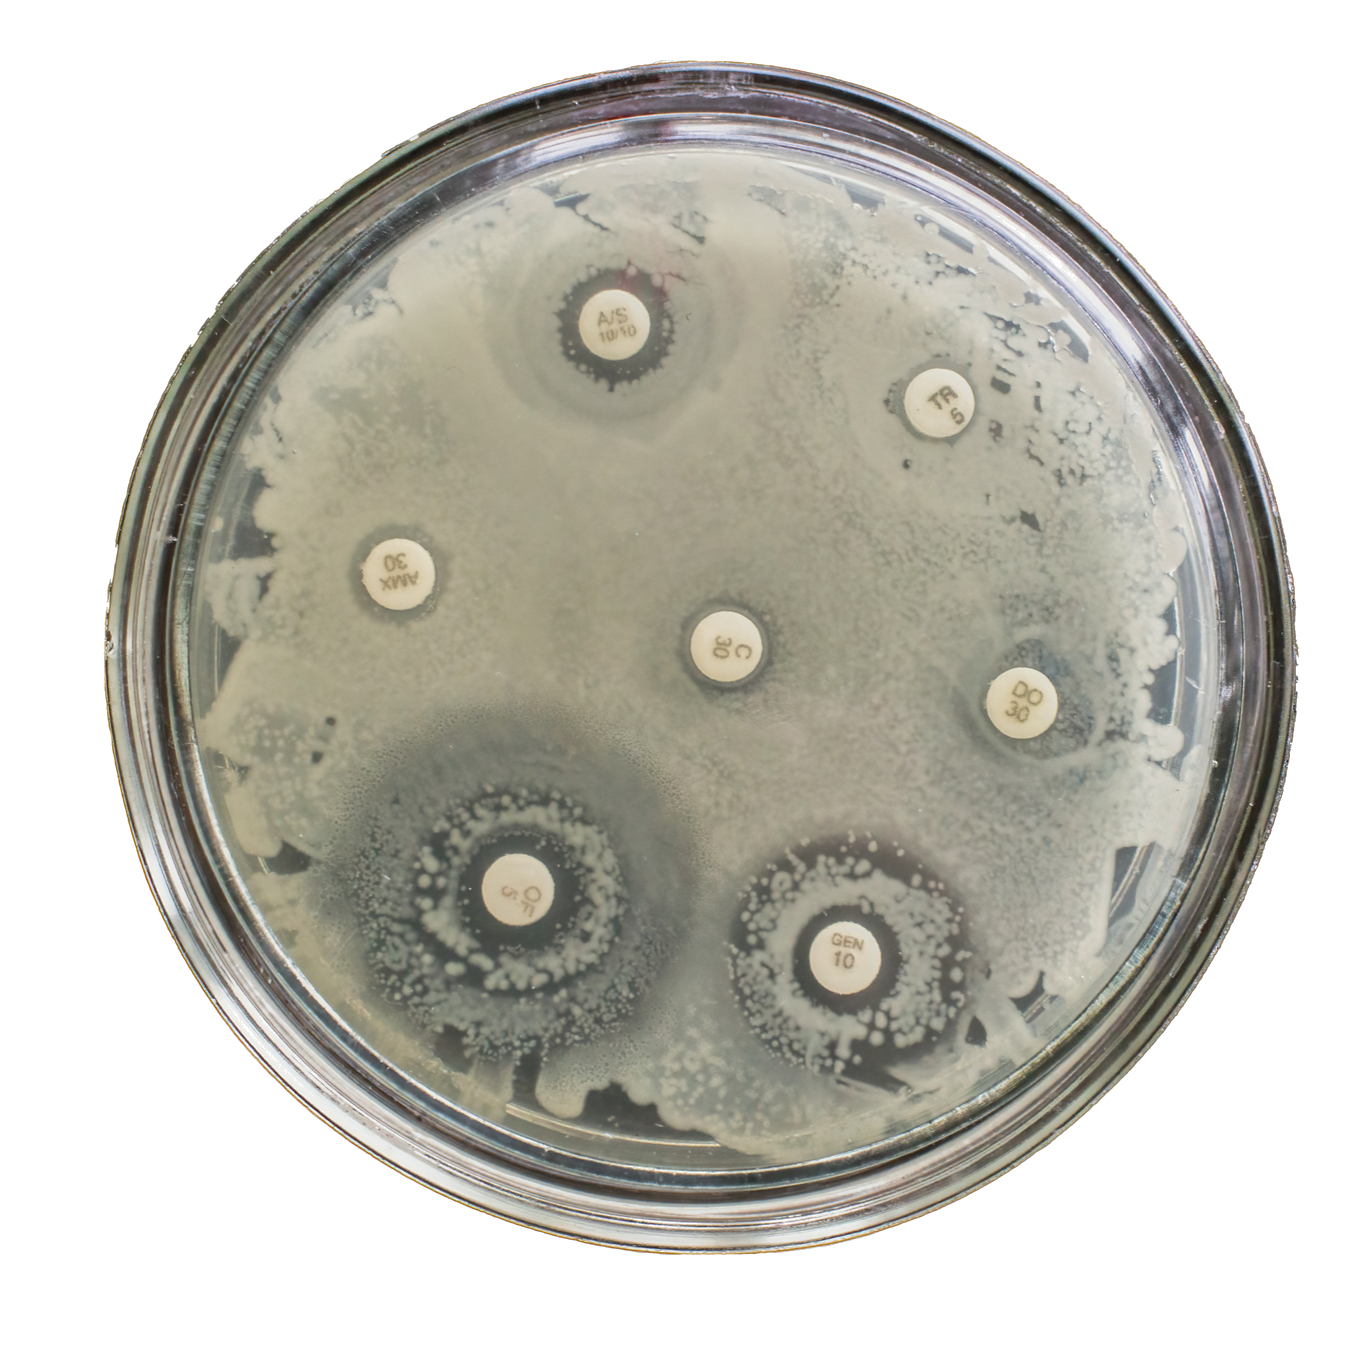
Header

El 15 de julio se lanzó formalmente el proyecto “RAM-MPTF: Lucha contra la resistencia a los antimicrobianos en Perú bajo el enfoque de Una salud”
El proyecto tendrá una duración de dos años y busca mejorar las capacidades de Perú para alcanzar los objetivos de su Plan de Acción Nacional contra la Resistencia a los Antimicrobianos, en línea con el Plan de Acción Global desarrollado por la Tripartita. La coordinación del proyecto estará a cargo de la Organización de las Naciones Unidas para la Alimentación y la Agricultura (FAO) y será implementado junto a la Organización Mundial de Sanidad Animal (OMSA) y la Organización Panamericana de la Salud (OPS).
El evento virtual contó con 120 participantes, incluyendo a representantes de la Tripartita y de distintas áreas del gobierno de Perú, así como representantes de la academia y público general.
La apertura del evento estuvo a cargo de Mariana Escobar Arango, Representante de FAO en Perú, seguida por Daniela Godoy Gabler, Oficial Superior de Políticas, Oficina Regional de la FAO para América Latina y el Caribe, y Mamissa Mboob, en representación del MPTF.
Luego de la apertura, Ronnie Gavilán, Secretario técnico de la Comisión Multisectorial contra la RAM y Mercedes Flores Cancino, Coordinadora General del Proyecto, presentaron los desafíos, oportunidades y avances en la contención de la Resistencia a los Antimicrobianos en Perú.
Finalmente, se presentó el contexto de la RAM en las Américas, y las acciones de la Alianza Tripartita bajo el Enfoque Una Salud. En este sentido, Marcelo Galas, del Programa especial de Resistencia a los Antimicrobianos, Enfermedades transmisibles y determinantes ambientales de la salud de OPS dio una perspectiva de la situación respecto a la RAM y el impacto de la pandemia de COVID-19.
Martín Minassian, Asistente Técnico de la Representación Regional de la OMSA para las Américas, dio una breve introducción a las acciones de la organización, y destacó los resultados del último reporte global sobre el uso de antimicrobianos en animales, donde se observa una notable reducción en el uso de antimicrobianos prioritarios, así como en su uso como promotores de crecimiento.
Finalmente, Marisa Caipo, Oficial Regional de Inocuidad de los Alimentos y Punto focal RAM de la FAO para América Latina y el Caribe, presentó las actividades desarrolladas en la región e hizo hincapié en la importancia de tener un enfoque coordinado entre todos los sectores, para abordar esta temática.
Acerca del MTPF
El Fondo Fiduciario de Asociados Múltiples para la Resistencia a los Antimicrobianos (MPTF) busca combatir la resistencia a los antimicrobianos mediante la colaboración estratégica, flujos de capital sostenibles y respuestas centradas en los Objetivos de Desarrollo Sostenible que apoyan los planes de acción nacionales localizados de “Una Salud”.